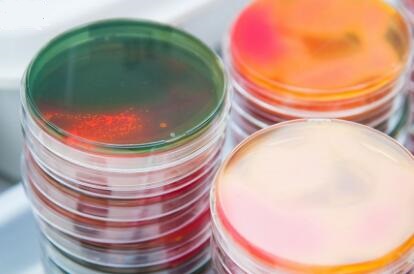
MS 基本培养基

MS 基本培养基
MURASHIGE AND SKOOG MODIFIED BASAL SALT MIXTURE
询价
250g/瓶
起订
上海 更新日期:2026-04-05
产品详情:
- 中文名称:
- MS 基本培养基
- 英文名称:
- MURASHIGE AND SKOOG MODIFIED BASAL SALT MIXTURE
- 产品类别:
- 培养基
- 产品名称:
- MS 基本培养基
- 货号:
- M5519-50L
公司简介
上海联硕生物科技有限公司成立于2010年,是一家专业经营生物、仪器、试剂、耗材的公司,在广大客户的支持及公司全体员工不懈的努力下,公司的服务和业务网络已遍及全国,成为了国内生命科学领域产品的主要供应商之一。自成立以来,联硕生物一直秉承客户至上、服务至诚;质量第一、诚信为本的理念,致力于做靠谱放心的专业服务商,助力您的科研成就!
| 成立日期 | (17年) |
| 注册资本 | 100万人民币 |
| 员工人数 | 50-100人 |
| 年营业额 | ¥ 100万-300万 |
| 经营模式 | 试剂,定制,服务 |
| 主营行业 | 生物化工 |
MS 基本培养基相关厂家报价 更多
-

- 猪乳固形物(MS)ELISA试剂盒
- 上海心语生物科技有限公司 VIP
- 2026-04-07
- ¥1280
-

- MS 基本培养基
- 青岛高科技工业园海博生物技术有限公司
- 2026-04-05
- 询价
-
![MS培养基基础[不含琼脂和蔗糖]](https://img.chemicalbook.com/SupplyImg/2020-06-02/Large/202006020856437812044.jpg)
- MS培养基基础[不含琼脂和蔗糖]
- 上海宾穗生物科技有限公司 VIP
- 2026-04-07
- ¥511
-

- 曲霉菌基本培养基基础
- 上海冠导生物工程有限公司 VIP
- 2026-04-07
- 询价
-

- 曲霉菌基本培养基:Aspergillus Minimal Medium
- 上海弘顺生物科技有限公司 VIP
- 2026-04-07
- 询价